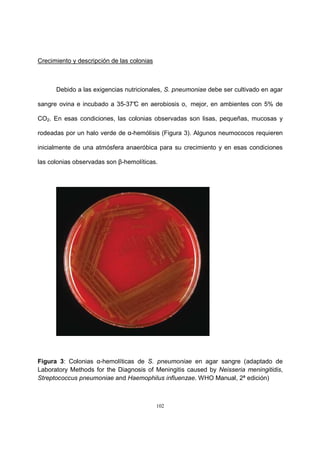
102
Crecimiento y descripción de las colonias
Debido a las exigencias nutricionales, S. pneumoniae debe ser cultivado en agar
sangre ovina e incubado a 35-37°C en aerobiosis o, mejor, en ambientes con 5% de
CO2. En esas condiciones, las colonias observadas son lisas, pequeñas, mucosas y
rodeadas por un halo verde de α-hemólisis (Figura 3). Algunos neumococos requieren
inicialmente de una atmósfera anaeróbica para su crecimiento y en esas condiciones
las colonias observadas son β-hemolíticas.
Figura 3: Colonias α-hemolíticas de S. pneumoniae en agar sangre (adaptado de
Laboratory Methods for the Diagnosis of Meningitis caused by Neisseria meningitidis,
Streptococcus pneumoniae and Haemophilus influenzae. WHO Manual, 2ª edición)
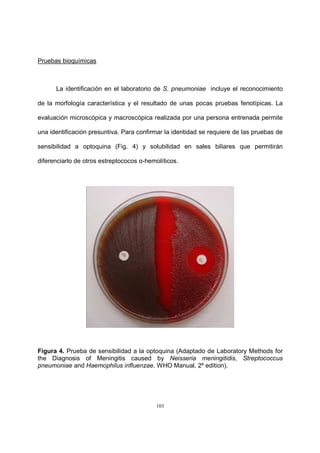
103
Pruebas bioquímicas
La identificación en el laboratorio de S. pneumoniae incluye el reconocimiento
de la morfología característica y el resultado de unas pocas pruebas fenotípicas. La
evaluación microscópica y macroscópica realizada por una persona entrenada permite
una identificación presuntiva. Para confirmar la identidad se requiere de las pruebas de
sensibilidad a optoquina (Fig. 4) y solubilidad en sales biliares que permitirán
diferenciarlo de otros estreptococos α-hemolíticos.
Figura 4. Prueba de sensibilidad a la optoquina (Adaptado de Laboratory Methods for
the Diagnosis of Meningitis caused by Neisseria meningitidis, Streptococcus
pneumoniae and Haemophilus influenzae. WHO Manual, 2º edition).
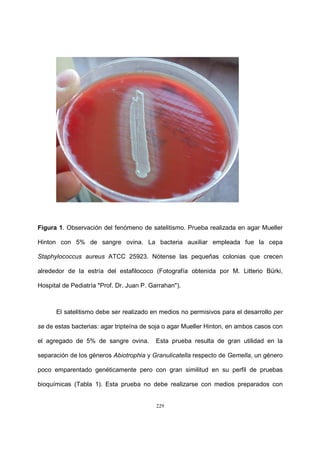
229
Figura 1. Observación del fenómeno de satelitismo. Prueba realizada en agar Mueller
Hinton con 5% de sangre ovina. La bacteria auxiliar empleada fue la cepa
Staphylococcus aureus ATCC 25923. Nótense las pequeñas colonias que crecen
alrededor de la estría del estafilococo (Fotografía obtenida por M. Litterio Bürki,
Hospital de Pediatría "Prof. Dr. Juan P. Garrahan").
El satelitismo debe ser realizado en medios no permisivos para el desarrollo per
se de estas bacterias: agar tripteína de soja o agar Mueller Hinton, en ambos casos con
el agregado de 5% de sangre ovina. Esta prueba resulta de gran utilidad en la
separación de los géneros Abiotrophia y Granulicatella respecto de Gemella, un género
poco emparentado genéticamente pero con gran similitud en su perfil de pruebas
bioquímicas (Tabla 1). Esta prueba no debe realizarse con medios preparados con

Este documento presenta un manual de microbiología clínica de bacterias de importancia clínica. Incluye capítulos sobre diferentes géneros y especies de cocos gram positivos catalasa negativos como estreptococos β-hemolíticos, Streptococcus pneumoniae, estreptococos del grupo viridans, enterococos y otras bacterias relacionadas como Abiotrophia, Granulicatella, Gemella y Aerococcus. Cada capítulo describe aspectos taxonómicos, hábitat, factores de virulencia, patogenia, identificación, sensibilidad a





























































![62
26. Camissa L, Fando E. Streptococcus agalactiae. Estudio de portación en embarazada y Ley
nacional N° 26.369/2008. Estrategia de Prevención. Investigación epidemiológica descriptiva-Ministerio
de Salud de la Pcia de Córdoba – Villa Caeiro, Córdoba – Argentina.
27. Campodónico L, Doren A, Cruz M, Abarzúa F. Profilaxis de sepsis neonatal precoz por
Streptococcus agalactiae (grupo B) basada en vacunas: revisión de la literatura. Rev Chil Obstet Ginecol.
2008;73:411-8.
28. Carapetis JR, Steer AC, Mulholland EK, Weber M. The global burden of group A streptococcal
diseases. Lancet Infect Dis. 2005;5:685-94.
29. Carapetis JR, Steer AC, Mulholland EK. The current evidence for the burden of group A
streptococcal diseases. Department of Child and Adolescent Health and Development, World Health
Organization, Geneva, Switzerland. 2005.
30. Carmeli Y, Ruoff KL. Report of cases and taxonomic considerations for large-colony-forming
Lancefield group C streptococcal bacteremia. J Clin Microbiol. 1995;33:2114-7.
31. Cecchini L, Pereyra R, Ottaviano S. Prevalencia y sensibilidad de Streptococcus agalactiae
aislados en mujeres embarazadas en el Hospital Zonal de Ezeiza. VII Congreso de SADEBAC, P160.
Buenos Aires, 25-30 de junio de 2012, Rev Argent Microbiol. 2012; 44 (Supl. 1): 70.
32. Centers for Disease Control and Prevention (CDC) Prevention of perinatal group B streptococcal
disease: revised guidelines from CDC. MMWR Morb Mortal Wkly Rep. 2002;51(RR-11):1-22
33. Centers for Disease Control and Prevention. Invasive infection due to Streptococcus iniae—
Ontario, 1995–1996. MMWR Morb Mortal Wkly Rep. 1996;45:650–3
34. Centers for Disease Control and Prevention. Prevention of perinatal group B streptococcus
disease: a public health perspective. MMWR. 1996;45 (RR-7): 1-24
35. Centers for Disease Control and Prevention. Adoption of hospital policies for prevention of
perinatal group B streptococcal disease - United States, 1997. MMWR. 1998;47:665-70.
36. Centers for Disease Control and Prevention. Streptococcus pyogenes emm sequence
database.2006 [Online] http://www.cdc.gov/ncidod/biotech/strep/emmtypes.htm
37. Chalker VJ, Brooks HW, Brownlie J. The association of Streptococcus equi subsp.
zooepidemicus with canine infectious respiratory disease. Vet Microbiol. 2003;95:149–156.](https://image.slidesharecdn.com/manualbacteriologiaclinica-160429001807/85/Manual-bacteriologia-clinica-62-320.jpg)

![119
22. Carvalho Mda G, Tondella ML, McCaustland K, Weidlich L, McGee L, Mayer LW, Steigerwalt A,
Whaley M, Facklam RR, Fields B, Carlone G, Ades EW, Dagan R, Sampson JS. Evaluation and
improvement of real-time PCR assays targeting lytA, ply, and psaA genes for detection of pneumococcal
DNA. J Clin Microbiol. 2007; 45: 2460-6.
23. Castañeda E, Agudelo CI, Regueira M, Corso A, Brandileone MC, Brandao AP, Maldonado A,
Hormazábal JC, Martínez IT, Llanes R, Sánchez J, Feris JM, Echaniz-Avilés G, Carnalla-Barajas MN,
Terrazas MG, Monroy IH, Chamorro G, Weiler N, Camou T, Gabarrot GG, Spadola E, Payares D,
Gabastou JM, Di Fabio JL, de la Hoz F. Laboratory-based surveillance of Streptococcus pneumoniae
invasive disease in children in 10 Latin American countries: a SIREVA II project, 2000-2005. Pediatr
Infect Dis J. 2009; 28: e265-70.
24. Centers for Disease Control and Prevention. Effects of new penicillin susceptibility breakpoints for
Streptococcus pneumoniae-United States, 2006-2007. MMWR 2008; 57: 1353-5.
25. Centers for Disease Control and Prevention and National Institutes of Health. Biosafety in
Microbiological and Biomedical Laboratories. Fifth Edition. U. S. Government Printing Office Washington,
2007.
26. Cochetti I, Tili E, Mingoia M, Varaldo PE, Montanari MP. erm(B)-carrying elements in tetracycline-
resistant pneumococci and correspondence between Tn1545 and Tn6003. Antimicrob Agents
Chemother. 2008; 52: 1285-90.
27. Constenla D, Gómez E, de la Hoz FP, O’Loughlin R, Sinha A, Valencia JE, Valenzuela MT. The
burden of pneumococcal disease and cost-effectiveness of a pneumococcal vaccine in Latin America and
the Caribbean: a review of the evidence and a preliminary economic analysis. 2007. [on line]
http://sabin.org.
28. Corso A, Faccone D, Gagetti P, Pace J, Regueira M. Prevalence of mef and ermB genes in
invasive pediatric erythromycin-resistant Streptococcus pneumoniae isolates from Argentina. Rev Argent
Microbiol. 2009; 41: 29-33.
29. Corso A, Fossati S, Gagetti P, Prieto N, Rodríguez M, Sorhouet C, Lamy P, Regueira M, Gentile
A. Comparison between invasive disease and nasopharyngeal carriage of S. pneumoniae among non
vaccinated Argentinean children during 2007/08. ISPPD, 2012, Foz de Iguazú, Brasil.](https://image.slidesharecdn.com/manualbacteriologiaclinica-160429001807/85/Manual-bacteriologia-clinica-119-320.jpg)































































































![215
58. Jones RN, Kohno S, Ono Y, Ross JE, Yanagihara K. ZAAPS international surveillance program
(2007) for linezolid resistance: results from 5591 gram-positive clinical isolates in 23 countries. Diagn
Microbiol Infect Dis. 2009;64:191-201.
59. Kainer MA, Devasia RA, Jones TF, Simmons BP, Melton K, Chow S, Broyles J, Moore KL, Craig
AS, Schaffner W. Response to emerging infection leading to outbreak of linezolid-resistant enterococci.
Emerg Infect Dis. 2007;13:1024-30.
60. Kernodle DS. Mechanisms of resistance to ß-lactam antibiotics. p.609-20 En: Fischetti VA,
Novick RP, Ferretti JJ, Portnoy DA, Rood JI (ed.) Gram-positive pathogens. ASM Press, 2000.
61. Khardori N, Wong E, Carrasco CH, Wallace S, Patt Y, Bodey GP. Infections associated with
biliary drainage procedures in patients with cancer. Rev Infect Dis. 1991;13:587-91.
62. Kim JH, Go J, Cho CG, Kim JI, Lee MS, Park SC. First report of human acute acalculous
cholecystitis caused by the fish pathogen Lactococcus garvieae. J Clin Microbiol. 2013;51:712-4.
63. Korczynska M, Mukhtar T, Wright G, Berghuis AM. Structural basis for streptogramin B resistance
in Staphylococcus aureus by virginiamycin B lyase. Proc Natl Acad Sci USA. 2007;104:10388–93.
64. Kristich CJ, Rice LB, Arias CA. Enterococcal infection — Treatment and antibiotic resistance.
En: Gilmore MS, Clewell DB, Ike Y, Shankar N, (ed.). Enterococci: from commensals to leading causes of
drug resistant infection [Internet]. Boston: Massachusetts Eye and Ear Infirmary; 2014.
65. Lai KK, Treatment of vancomycin resistant Enterococcus faecium infections. Arch Intern Med.
1996;156:2579-84.
66. Lauridsen TK, Bruun LE, Rasmussen RV, Arpi M, Risum N, Moser C, Johansen HK, Bundgaard
H, Hassager C, Bruun NE. Linezolid as rescue treatment for left-sided infective endocarditis: an
observational, retrospective, multicenter study. Eur J Clin Microbiol Infect Dis. 2012;31:2567-74.
67. Laverde Gómez JA, Hendrickx APA, Willems RJ, Top J, Sava I, Huebner J, Witte W, Werner G.
Intra- and interspecies genomic transfer of the Enterococcus faecalis pathogenicity island. PLoS ONE.
2011; 6: e16720.
68. Leavis HL, Willems RJ, Van Wamel WJ, Schuren FH, Caspers MP, Bonten MJ. Insertion
sequence-driven diversification creates a globally dispersed emerging multiresistant subspecies of E.
faecium. PLoS Pathog. 2007;3:e7.](https://image.slidesharecdn.com/manualbacteriologiaclinica-160429001807/85/Manual-bacteriologia-clinica-215-320.jpg)









![225
y a ellas se puede recurrir para ampliar algunos aspectos que en este capítulo puedan
estar acotados 109, 134, 135
.
Por razones prácticas se utilizará la sigla VNS para referirse en conjunto a los
microorganismos incluidos en estos dos géneros. Primariamente se los describió como
formas L de estreptococos que desarrollaban auxiliados por otras bacterias
(satelitismo)61
. Sus requerimientos nutricionales [dependencia de clorhidrato de
piridoxal (ClHP) y/o clorhidrato de cisteína (ClHCys)], su variabilidad en la coloración
de Gram, su pleomorfismo y su microaerofilia fueron destacados a posteriori por
varios autores23, 25, 115
.
Al principio se los consideró mutantes deficientes de especies previamente
conocidas dentro de los estreptococos del grupo viridans23, 47
, basándose en
resultados de pruebas de fermentación de azúcares, en los porcentajes de contenido
de ramnosa de su pared celular131
y en .la producción de un cromóforo rosado-rojo que
se encuentra localizado en la pared celular153
. Bouvet et al., concluyeron que se
trataba de un grupo diferente de bacterias17
. Se observó que daban positiva la prueba
de pirrolidonilarilamidasa (PYR) y que bioquímicamente se comportaban en forma
heterogénea como para conformar tres biotipos distintos que fueron incluidos en dos
especies: Streptococcus defectivus y Streptococcus adjacens (dos subespecies)16
.
El estudio de las secuencias del ARNr 16S de las cepas "tipo" o de referencia de
estas especies permitió establecer un nuevo género, Abiotrophia en el que ambas
especies quedaban incluidas. Las especies fueron denominadas Abiotrophia defectiva
y Abiotrophia adiacens81
. Luego fueron agregadas nuevas especies: Abiotrophia
elegans133
, Abiotrophia balaenopterae, aislada de ballenas97
y Abiotrophia para-](https://image.slidesharecdn.com/manualbacteriologiaclinica-160429001807/85/Manual-bacteriologia-clinica-225-320.jpg)

![232
frecuente de las VNS en los casos de endocarditis infecciosa humana. También estos
microorganismos fueron aislados de la cavidad oral de los perros54
.
Tabla 2. Características fenotípicas utilizadas en la identificación de las VNS a nivel de
especie [adaptada de Christensen y Facklam28
y Kanamoto et al.81
]
Característica
fenotípica
A. defectiva G. adiacens G. para-adiacens G. elegans
α-galactosidasa + - - -
β-galactosidasa + + - -
β-glucuronidasa - + ND -
Fosfatasa alcalina - - ND -
α-fucosidasa + + ND -
Acetoína - - ND -
Arginina - - - +
Hipurato - - ND +
Inulina - - ND -
Lactosa + - ND -
Maltosa + + ND -
Rafinosa - - ND -
Sacarosa + + + +
Trehalosa + - - -
Amigdalina - - ND -
Salicina - - ND -
Pululano + - - -
Tagatosa - + - -
+, >90% de los aislamientos son positivos; -, <10% de los aislamientos son positivos; ND: no determinado.
Las VNS fueron predominantemente aisladas a partir de muestras de sangre en
los laboratorios de microbiología clínica28
. Varios casos aislados de bacteriemias sin
endocarditis también se publicaron a lo largo de los años, incluso se reconoció a G.
adiacens como agente de sepsis neonatal precoz11, 100, 102, 107
. Son raros los casos de](https://image.slidesharecdn.com/manualbacteriologiaclinica-160429001807/85/Manual-bacteriologia-clinica-232-320.jpg)



































































